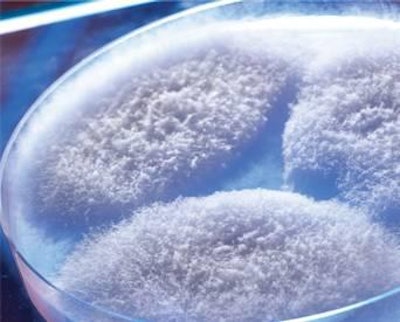

Fusarium proliferatrum (shown above), and F verticilloides.
Fumonisins are a group of harmful fungal metabolites mainly produced by Fusariumproliferatum and F. verticillioides and which, when present in feed, can have a serious impact on the performance of poultry flocks.
Metabolic and immunologic impact
Inside the chicken
Fumonisin prevalence
The occurrence of fumonisins is ubiquitous and not limited to a specific climate.
Effective mycotoxin risk management, including novel approaches to biotransformation, is essential to help birds face fumonisin-induced impairment of the immune and digestive system, and to help maximize performance.
















